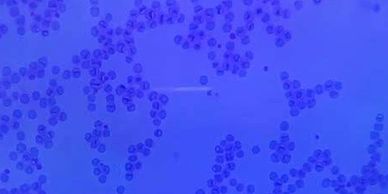

Our surgeries are carried out in our new state of the art facility which comprises a large prep room and two theatres. Surgeries are done Monday to Friday after our Consults Clinic.
Our daily surgery list would usually range from routine neutering of cats, dogs, rabbits, ferrets and guinea pigs. There would also be dental work cases on the list which would include x-rays, descaling, polishing and where necessary extractions.
We also carry out cruciate repair surgery.
Not all surgeries are planned and on occasions emergencies present themselves, an example being Cesarean Sections.


Faecal Sample
Blood Smear

Ear Mites

Urinary Crystals

Semen sample


.

We also have a complete in-house laboratory consisting of blood machines, microscope, and urine testing equipment. This means that should your pet ever require a blood test we have a biochemistry and haematology machine available to allow quick and accurate results. If your pet requires more specialised tests, we have access to external accredited labs to run these samples for us.
.

Our Blood Reading machine

Blood Sampling Bottles

Refractometer for testing urine samples

Glucometer for testing our Diabetic patients

Our Centrifuge machine which spins blood samples in order to separate the cells and the serum in the sample

Our Biochemistry Machine

Our Otoscope and Auriscope
This image willl give you an idea how the Otoscope and Auriscope are used in examining patients suffering with their ears
The stethoscope - used to check every patient's heart
-
--
